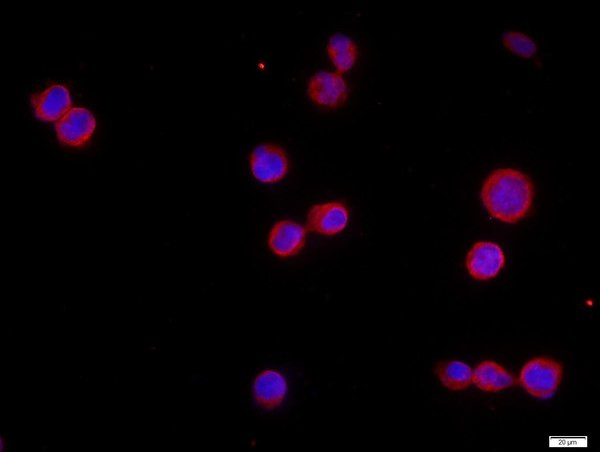
CHRNA7 Antibody in Immunocytochemistry (ICC/IF)

Search
Bioss
CHRNA7 Polyclonal Antibody
{{$productOrderCtrl.translations['antibody.pdp.commerceCard.promotion.promotions']}}
{{$productOrderCtrl.translations['antibody.pdp.commerceCard.promotion.viewpromo']}}
{{$productOrderCtrl.translations['antibody.pdp.commerceCard.promotion.promocode']}}: {{promo.promoCode}} {{promo.promoTitle}} {{promo.promoDescription}}. {{$productOrderCtrl.translations['antibody.pdp.commerceCard.promotion.learnmore']}}
图: 1 / 6
CHRNA7 Antibody (BS-1049R) in ICC/IF






产品信息
BS-1049R
种属反应
宿主/亚型
分类
类型
抗原
偶联物
形式
浓度
规格
纯化类型
保存液
内含物
保存条件
运输条件
靶标信息
Chromosome 15 encodes over 700 genes and comprises nearly 3% of the human genome. CHRFAM7A, a fusion protein comprised of FAM7A and AChR alpha7, is encoded by the CHRFAM7A gene, which is located on a region of human chromosome 15 that is associated with several neuropsychiatric disorders, such as schizophrenia and bipolar affective disorder. CHRFAM7A, also known as D-10 or CHRNA7, is a 412 amino acid multi-pass membrane protein that belongs to the nicotinic acetylcholine receptor (nAChR) subfamily of ligand-gated ion channel proteins, a protein superfamily that mediates signal transmission at synapses. CHRFAM7A is expressed in the hippocampus. Alternative splicing of the CHRFAM7A gene produces two splice variants.
仅用于科研。不用于诊断过程。未经明确授权不得转售。
篇参考文献 (0)
生物信息学
蛋白别名: a7 nicotinic acetylcholine receptor; acetylcholine receptor; acetylcholine receptor alpha 7 neural; alpha 7 neuronal nicotinic acetylcholine receptor; alpha-7 nicotinic cholinergic receptor subunit; alpha7 nicotinic receptor; alpha7-nAChR; bungarotoxin alpha; C holinergic receptor nicotinic alpha polypeptide 7 (neuronal nicotinic acetycholine receptor alpha 7) (bungarotoxin alpha); C holinergic receptor, nicotinic, alpha polypeptide 7 (neuronal nicotinic acetycholine receptor alpha 7) (bungarotoxin alpha); cholinergic receptor; cholinergic receptor, nicotinic alpha 7; cholinergic receptor, nicotinic, alpha 7 (neuronal); cholinergic receptor, nicotinic, alpha polypeptide 7; CHRFAM7A; CHRNA7-DR1; cytotransmitter gated ion channel; D-10; nAChR alpha7; nAChR7; neuronal acetylcholine receptor protein, alpha-7 chain; Neuronal acetylcholine receptor subunit alpha-7; neuronal nicotinic acetycholine receptor alpha 7; Nicotinic acetylcholine receptor subunit alpha-7; nicotinic receptor alpha 7 subunit; unnamed protein product
基因别名: Acra7; alpha7; BTX; CHRNA7; CHRNA7-2; nAchR; nAChR7; NACHRA7; NARAD
UniProt ID: (Human) P36544, (Rat) Q05941, (Mouse) P49582
Entrez Gene ID: (Human) 1139, (Rat) 25302, (Mouse) 11441